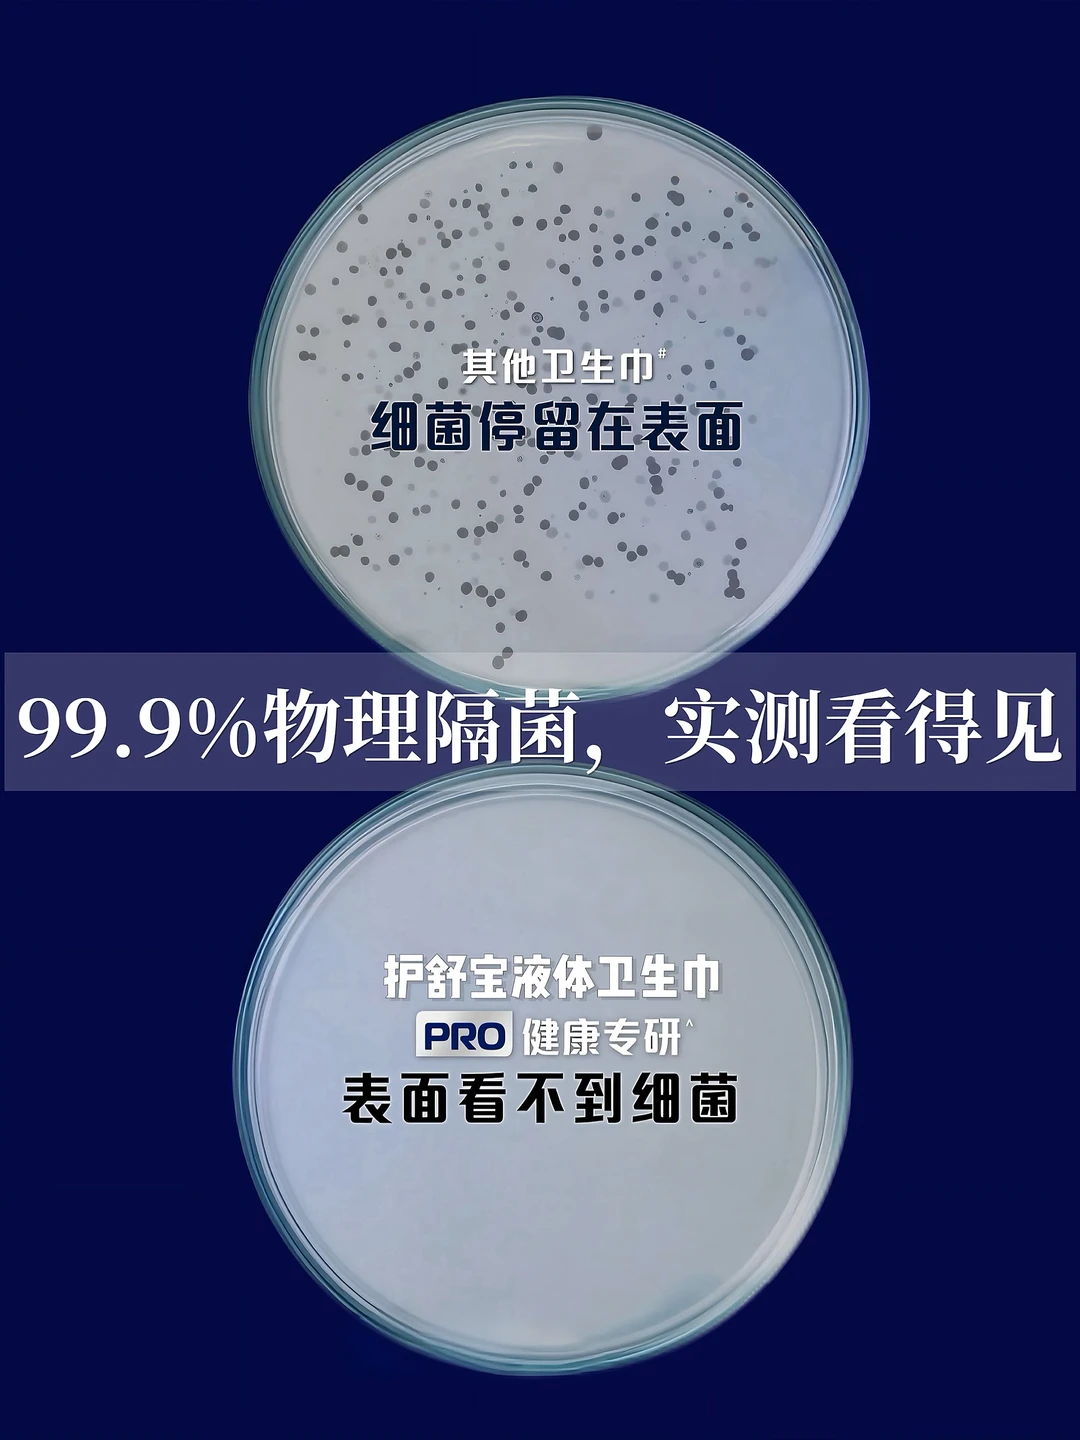

最近冬天天气越来越凉,总是感觉身体沉甸甸的,这会儿不仅要好好提高身体抵抗力,更要吃好!
特别是在经期,喝上一碗热腾腾的汤真的好舒服!!!
今天吃的是白萝卜肉丸汤+肉末豆腐抱蛋+玉米杂粮饭
有肉有汤,有饭有菜~干净清淡,却又不失滋味!
肠胃和身心都超满足[萌萌哒R]
关键还特别好上手!!
手残党姐妹也能跟我一起学起来~
.
🍲 所需食材:猪肉末、白萝卜、嫩豆腐、鸡蛋、葱姜蒜
具体做法在P4&12哦~期待各位的分享!!
.
一碗热汤下去,身体一下子都暖了~
其实女生们都懂,在月经期间,
身体真的太容易敏感难受了!
再加上最近入冬温差大,感觉抵抗力都差了
抵抗力一差尤其是在经期特别能感受出来,
总是黏黏的很闷痒……[哭惹R]
研究了一把才发现,其实主要是卫生巾没用对
让经血长期接触着皮肤,加上抵抗力一下降,
就很容易让细菌钻空子!
所以呀,这几天除了要吃好,外用的卫生巾也可要好好选选,内外兼修才是爱自己呢!
还好上次去月子中心看闺蜜的时候遇到了这款
👉全新上市的护舒宝物理隔菌卫生巾,
上次也就临时借闺蜜的用了一次,就立马爱上了!
这款卫生巾做到了99.9%的物理隔菌❗️
就像是给肌肤搭建了一个物理隔菌盾,把经血细菌统统隔离在了底部[赞R]
反渗不上来,自然也就干干爽爽啦!
所以不管是上班久坐,
还是像我这样经常性做饭忙得没空换的[完啦R]
都不用再担心会有湿哒哒的闷在那里的感觉了!
怪不得产后妈妈这么敏感的肌肤也能放心用她!
真不愧是央妈认证的卫生巾呀~~
关键表面用的还是婴儿级类肤材料!
软软的很亲肤,对皮肤没啥刺激
敏感人群也可以放心用!经期使用超舒适~
宝子们,再忙也要记得好好吃饭,经期更要照顾好自己哦!